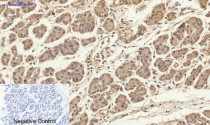

ARG66190
anti-Smad 2 antibody
anti-Smad 2 antibody for IHC-Formalin-fixed paraffin-embedded sections and Human,Mouse,Rat
Overview
| Product Description | Rabbit Polyclonal antibody recognizes Smad 2 |
|---|---|
| Tested Reactivity | Hu, Ms, Rat |
| Tested Application | IHC-P |
| Specificity | The antibody detects endogenous Smad2 protein. |
| Host | Rabbit |
| Clonality | Polyclonal |
| Isotype | IgG |
| Target Name | Smad 2 |
| Antigen Species | Human |
| Immunogen | Synthetic peptide around aa. 410-490 of Human Smad2. |
| Conjugation | Un-conjugated |
| Alternate Names | SMAD family member 2; MADR2; MADH2; Mothers against decapentaplegic homolog 2; JV18; Smad2; hMAD-2; Mad-related protein 2; hSMAD2; Mothers against DPP homolog 2; JV18-1; MAD homolog 2; SMAD 2 |
Application Instructions
| Application Suggestion |
|
||||
|---|---|---|---|---|---|
| Application Note | IHC-P: Antigen Retrieval: Boil tissue section in Sodium citrate buffer (pH 6.0) for 20 min. * The dilutions indicate recommended starting dilutions and the optimal dilutions or concentrations should be determined by the scientist. |
Properties
| Form | Liquid |
|---|---|
| Purification | Affinity purification with immunogen. |
| Buffer | PBS, 0.02% Sodium azide, 50% Glycerol and 0.5% BSA. |
| Preservative | 0.02% Sodium azide |
| Stabilizer | 50% Glycerol and 0.5% BSA |
| Concentration | 1 mg/ml |
| Storage Instruction | For continuous use, store undiluted antibody at 2-8°C for up to a week. For long-term storage, aliquot and store at -20°C. Storage in frost free freezers is not recommended. Avoid repeated freeze/thaw cycles. Suggest spin the vial prior to opening. The antibody solution should be gently mixed before use. |
| Note | For laboratory research only, not for drug, diagnostic or other use. |
Bioinformation
| Database Links | |
|---|---|
| Gene Symbol | SMAD2 |
| Gene Full Name | SMAD family member 2 |
| Background | The protein encoded by this gene belongs to the SMAD, a family of proteins similar to the gene products of the Drosophila gene 'mothers against decapentaplegic' (Mad) and the C. elegans gene Sma. SMAD proteins are signal transducers and transcriptional modulators that mediate multiple signaling pathways. This protein mediates the signal of the transforming growth factor (TGF)-beta, and thus regulates multiple cellular processes, such as cell proliferation, apoptosis, and differentiation. This protein is recruited to the TGF-beta receptors through its interaction with the SMAD anchor for receptor activation (SARA) protein. In response to TGF-beta signal, this protein is phosphorylated by the TGF-beta receptors. The phosphorylation induces the dissociation of this protein with SARA and the association with the family member SMAD4. The association with SMAD4 is important for the translocation of this protein into the nucleus, where it binds to target promoters and forms a transcription repressor complex with other cofactors. This protein can also be phosphorylated by activin type 1 receptor kinase, and mediates the signal from the activin. Alternatively spliced transcript variants have been observed for this gene. [provided by RefSeq, May 2012] |
| Function | Receptor-regulated SMAD (R-SMAD) that is an intracellular signal transducer and transcriptional modulator activated by TGF-beta (transforming growth factor) and activin type 1 receptor kinases. Binds the TRE element in the promoter region of many genes that are regulated by TGF-beta and, on formation of the SMAD2/SMAD4 complex, activates transcription. May act as a tumor suppressor in colorectal carcinoma. Positively regulates PDPK1 kinase activity by stimulating its dissociation from the 14-3-3 protein YWHAQ which acts as a negative regulator. [UniProt] |
| Calculated MW | 52 kDa |
| PTM | Phosphorylated on one or several of Thr-220, Ser-245, Ser-250, and Ser-255. In response to TGF-beta, phosphorylated on Ser-465/467 by TGF-beta and activin type 1 receptor kinases. TGF-beta-induced Ser-465/467 phosphorylation declines progressively in a KMT5A-dependent manner. Able to interact with SMURF2 when phosphorylated on Ser-465/467, recruiting other proteins, such as SNON, for degradation. In response to decorin, the naturally occurring inhibitor of TGF-beta signaling, phosphorylated on Ser-240 by CaMK2. Phosphorylated by MAPK3 upon EGF stimulation; which increases transcriptional activity and stability, and is blocked by calmodulin. Phosphorylated by PDPK1. In response to TGF-beta, ubiquitinated by NEDD4L; which promotes its degradation. Monoubiquitinated, leading to prevent DNA-binding (By similarity). Deubiquitination by USP15 alleviates inhibition and promotes activation of TGF-beta target genes (PubMed:21947082). Ubiquitinated by RNF111, leading to its degradation: only SMAD2 proteins that are 'in use' are targeted by RNF111, RNF111 playing a key role in activating SMAD2 and regulating its turnover (By similarity). Acetylated on Lys-19 by coactivators in response to TGF-beta signaling, which increases transcriptional activity. Isoform short: Acetylation increases DNA binding activity in vitro and enhances its association with target promoters in vivo. Acetylation in the nucleus by EP300 is enhanced by TGF-beta. |
Images (21) Click the Picture to Zoom In
-
ARG66190 anti-Smad 2 antibody IHC-P image
Immunohistochemistry: Paraffin-embedded Human uterus tissue stained with ARG66190 anti-Smad 2 antibody at 1:200 dilution (4°C, overnight). Antigen Retrieval: Boil tissue section in Sodium citrate buffer (pH 6.0) for 20 min.
Negative control was used by secondary antibody only.
-
ARG66190 anti-Smad 2 antibody IHC-P image
Immunohistochemistry: Paraffin-embedded Human uterus cancer tissue stained with ARG66190 anti-Smad 2 antibody at 1:200 dilution (4°C, overnight). Antigen Retrieval: Boil tissue section in Sodium citrate buffer (pH 6.0) for 20 min.
Negative control was used by secondary antibody only.
-
ARG66190 anti-Smad 2 antibody IHC-P image
Immunohistochemistry: Paraffin-embedded Human lung cancer tissue stained with ARG66190 anti-Smad 2 antibody at 1:200 dilution (4°C, overnight). Antigen Retrieval: Boil tissue section in Sodium citrate buffer (pH 6.0) for 20 min.
Negative control was used by secondary antibody only.
-
ARG66190 anti-Smad 2 antibody IHC-P image
Immunohistochemistry: Paraffin-embedded Human stomach tissue stained with ARG66190 anti-Smad 2 antibody at 1:200 dilution (4°C, overnight). Antigen Retrieval: Boil tissue section in Sodium citrate buffer (pH 6.0) for 20 min.
Negative control was used by secondary antibody only.
-
ARG66190 anti-Smad 2 antibody IHC-P image
Immunohistochemistry: Paraffin-embedded Human stomach cancer tissue stained with ARG66190 anti-Smad 2 antibody at 1:200 dilution (4°C, overnight). Antigen Retrieval: Boil tissue section in Sodium citrate buffer (pH 6.0) for 20 min.
Negative control was used by secondary antibody only.
-
ARG66190 anti-Smad 2 antibody IHC-P image
Immunohistochemistry: Paraffin-embedded Human Appendix tissue stained with ARG66190 anti-Smad 2 antibody at 1:200 dilution (4°C, overnight). Antigen Retrieval: Boil tissue section in Sodium citrate buffer (pH 6.0) for 20 min.
Negative control was used by secondary antibody only.
-
ARG66190 anti-Smad 2 antibody IHC-P image
Immunohistochemistry: Paraffin-embedded Rat heart tissue stained with ARG66190 anti-Smad 2 antibody at 1:200 dilution (4°C, overnight). Antigen Retrieval: Boil tissue section in Sodium citrate buffer (pH 6.0) for 20 min.
Negative control was used by secondary antibody only.
-
ARG66190 anti-Smad 2 antibody IHC-P image
Immunohistochemistry: Paraffin-embedded Rat testis tissue stained with ARG66190 anti-Smad 2 antibody at 1:200 dilution (4°C, overnight). Antigen Retrieval: Boil tissue section in Sodium citrate buffer (pH 6.0) for 20 min.
Negative control was used by secondary antibody only.
-
ARG66190 anti-Smad 2 antibody IHC-P image
Immunohistochemistry: Paraffin-embedded Rat liver tissue stained with ARG66190 anti-Smad 2 antibody at 1:200 dilution (4°C, overnight). Antigen Retrieval: Boil tissue section in Sodium citrate buffer (pH 6.0) for 20 min.
Negative control was used by secondary antibody only.
-
ARG66190 anti-Smad 2 antibody IHC-P image
Immunohistochemistry: Paraffin-embedded Rat lung tissue stained with ARG66190 anti-Smad 2 antibody at 1:200 dilution (4°C, overnight). Antigen Retrieval: Boil tissue section in Sodium citrate buffer (pH 6.0) for 20 min.
Negative control was used by secondary antibody only.
-
ARG66190 anti-Smad 2 antibody IHC-P image
Immunohistochemistry: Paraffin-embedded Rat kidney tissue stained with ARG66190 anti-Smad 2 antibody at 1:200 dilution (4°C, overnight). Antigen Retrieval: Boil tissue section in Sodium citrate buffer (pH 6.0) for 20 min.
Negative control was used by secondary antibody only.
-
ARG66190 anti-Smad 2 antibody IHC-P image
Immunohistochemistry: Paraffin-embedded Rat spinal-cord tissue stained with ARG66190 anti-Smad 2 antibody at 1:200 dilution (4°C, overnight). Antigen Retrieval: Boil tissue section in Sodium citrate buffer (pH 6.0) for 20 min.
Negative control was used by secondary antibody only.
-
ARG66190 anti-Smad 2 antibody IHC-P image
Immunohistochemistry: Paraffin-embedded Rat brain tissue stained with ARG66190 anti-Smad 2 antibody at 1:200 dilution (4°C, overnight). Antigen Retrieval: Boil tissue section in Sodium citrate buffer (pH 6.0) for 20 min.
Negative control was used by secondary antibody only.
-
ARG66190 anti-Smad 2 antibody IHC-P image
Immunohistochemistry: Paraffin-embedded Rat spleen tissue stained with ARG66190 anti-Smad 2 antibody at 1:200 dilution (4°C, overnight). Antigen Retrieval: Boil tissue section in Sodium citrate buffer (pH 6.0) for 20 min.
Negative control was used by secondary antibody only.
-
ARG66190 anti-Smad 2 antibody IHC-P image
Immunohistochemistry: Paraffin-embedded Mouse testis tissue stained with ARG66190 anti-Smad 2 antibody at 1:200 dilution (4°C, overnight). Antigen Retrieval: Boil tissue section in Sodium citrate buffer (pH 6.0) for 20 min.
Negative control was used by secondary antibody only.
-
ARG66190 anti-Smad 2 antibody IHC-P image
Immunohistochemistry: Paraffin-embedded Mouse colon tissue stained with ARG66190 anti-Smad 2 antibody at 1:200 dilution (4°C, overnight). Antigen Retrieval: Boil tissue section in Sodium citrate buffer (pH 6.0) for 20 min.
Negative control was used by secondary antibody only.
-
ARG66190 anti-Smad 2 antibody IHC-P image
Immunohistochemistry: Paraffin-embedded Mouse liver tissue stained with ARG66190 anti-Smad 2 antibody at 1:200 dilution (4°C, overnight). Antigen Retrieval: Boil tissue section in Sodium citrate buffer (pH 6.0) for 20 min.
Negative control was used by secondary antibody only.
-
ARG66190 anti-Smad 2 antibody IHC-P image
Immunohistochemistry: Paraffin-embedded Mouse lung tissue stained with ARG66190 anti-Smad 2 antibody at 1:200 dilution (4°C, overnight). Antigen Retrieval: Boil tissue section in Sodium citrate buffer (pH 6.0) for 20 min.
Negative control was used by secondary antibody only.
-
ARG66190 anti-Smad 2 antibody IHC-P image
Immunohistochemistry: Paraffin-embedded Mouse kidney tissue stained with ARG66190 anti-Smad 2 antibody at 1:200 dilution (4°C, overnight). Antigen Retrieval: Boil tissue section in Sodium citrate buffer (pH 6.0) for 20 min.
Negative control was used by secondary antibody only.
-
ARG66190 anti-Smad 2 antibody IHC-P image
Immunohistochemistry: Paraffin-embedded Mouse brain tissue stained with ARG66190 anti-Smad 2 antibody at 1:200 dilution (4°C, overnight). Antigen Retrieval: Boil tissue section in Sodium citrate buffer (pH 6.0) for 20 min.
Negative control was used by secondary antibody only.
-
ARG66190 anti-Smad 2 antibody IHC-P image
Immunohistochemistry: Paraffin-embedded Mouse spleen tissue stained with ARG66190 anti-Smad 2 antibody at 1:200 dilution (4°C, overnight). Antigen Retrieval: Boil tissue section in Sodium citrate buffer (pH 6.0) for 20 min.
Negative control was used by secondary antibody only.